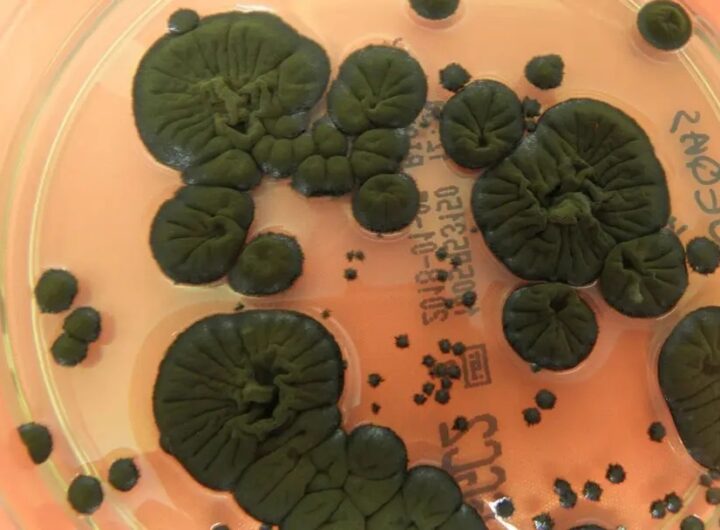
Технології - NASA розглядає чорнобильські гриби як новий захист від радіації в космосі

admin
6 місяців ago
Фільм “Хижак: Дикі землі” став найпопулярнішою частиною франшизи “Хижак”. Він обійшов у касових зборах всі попередні фільми,...